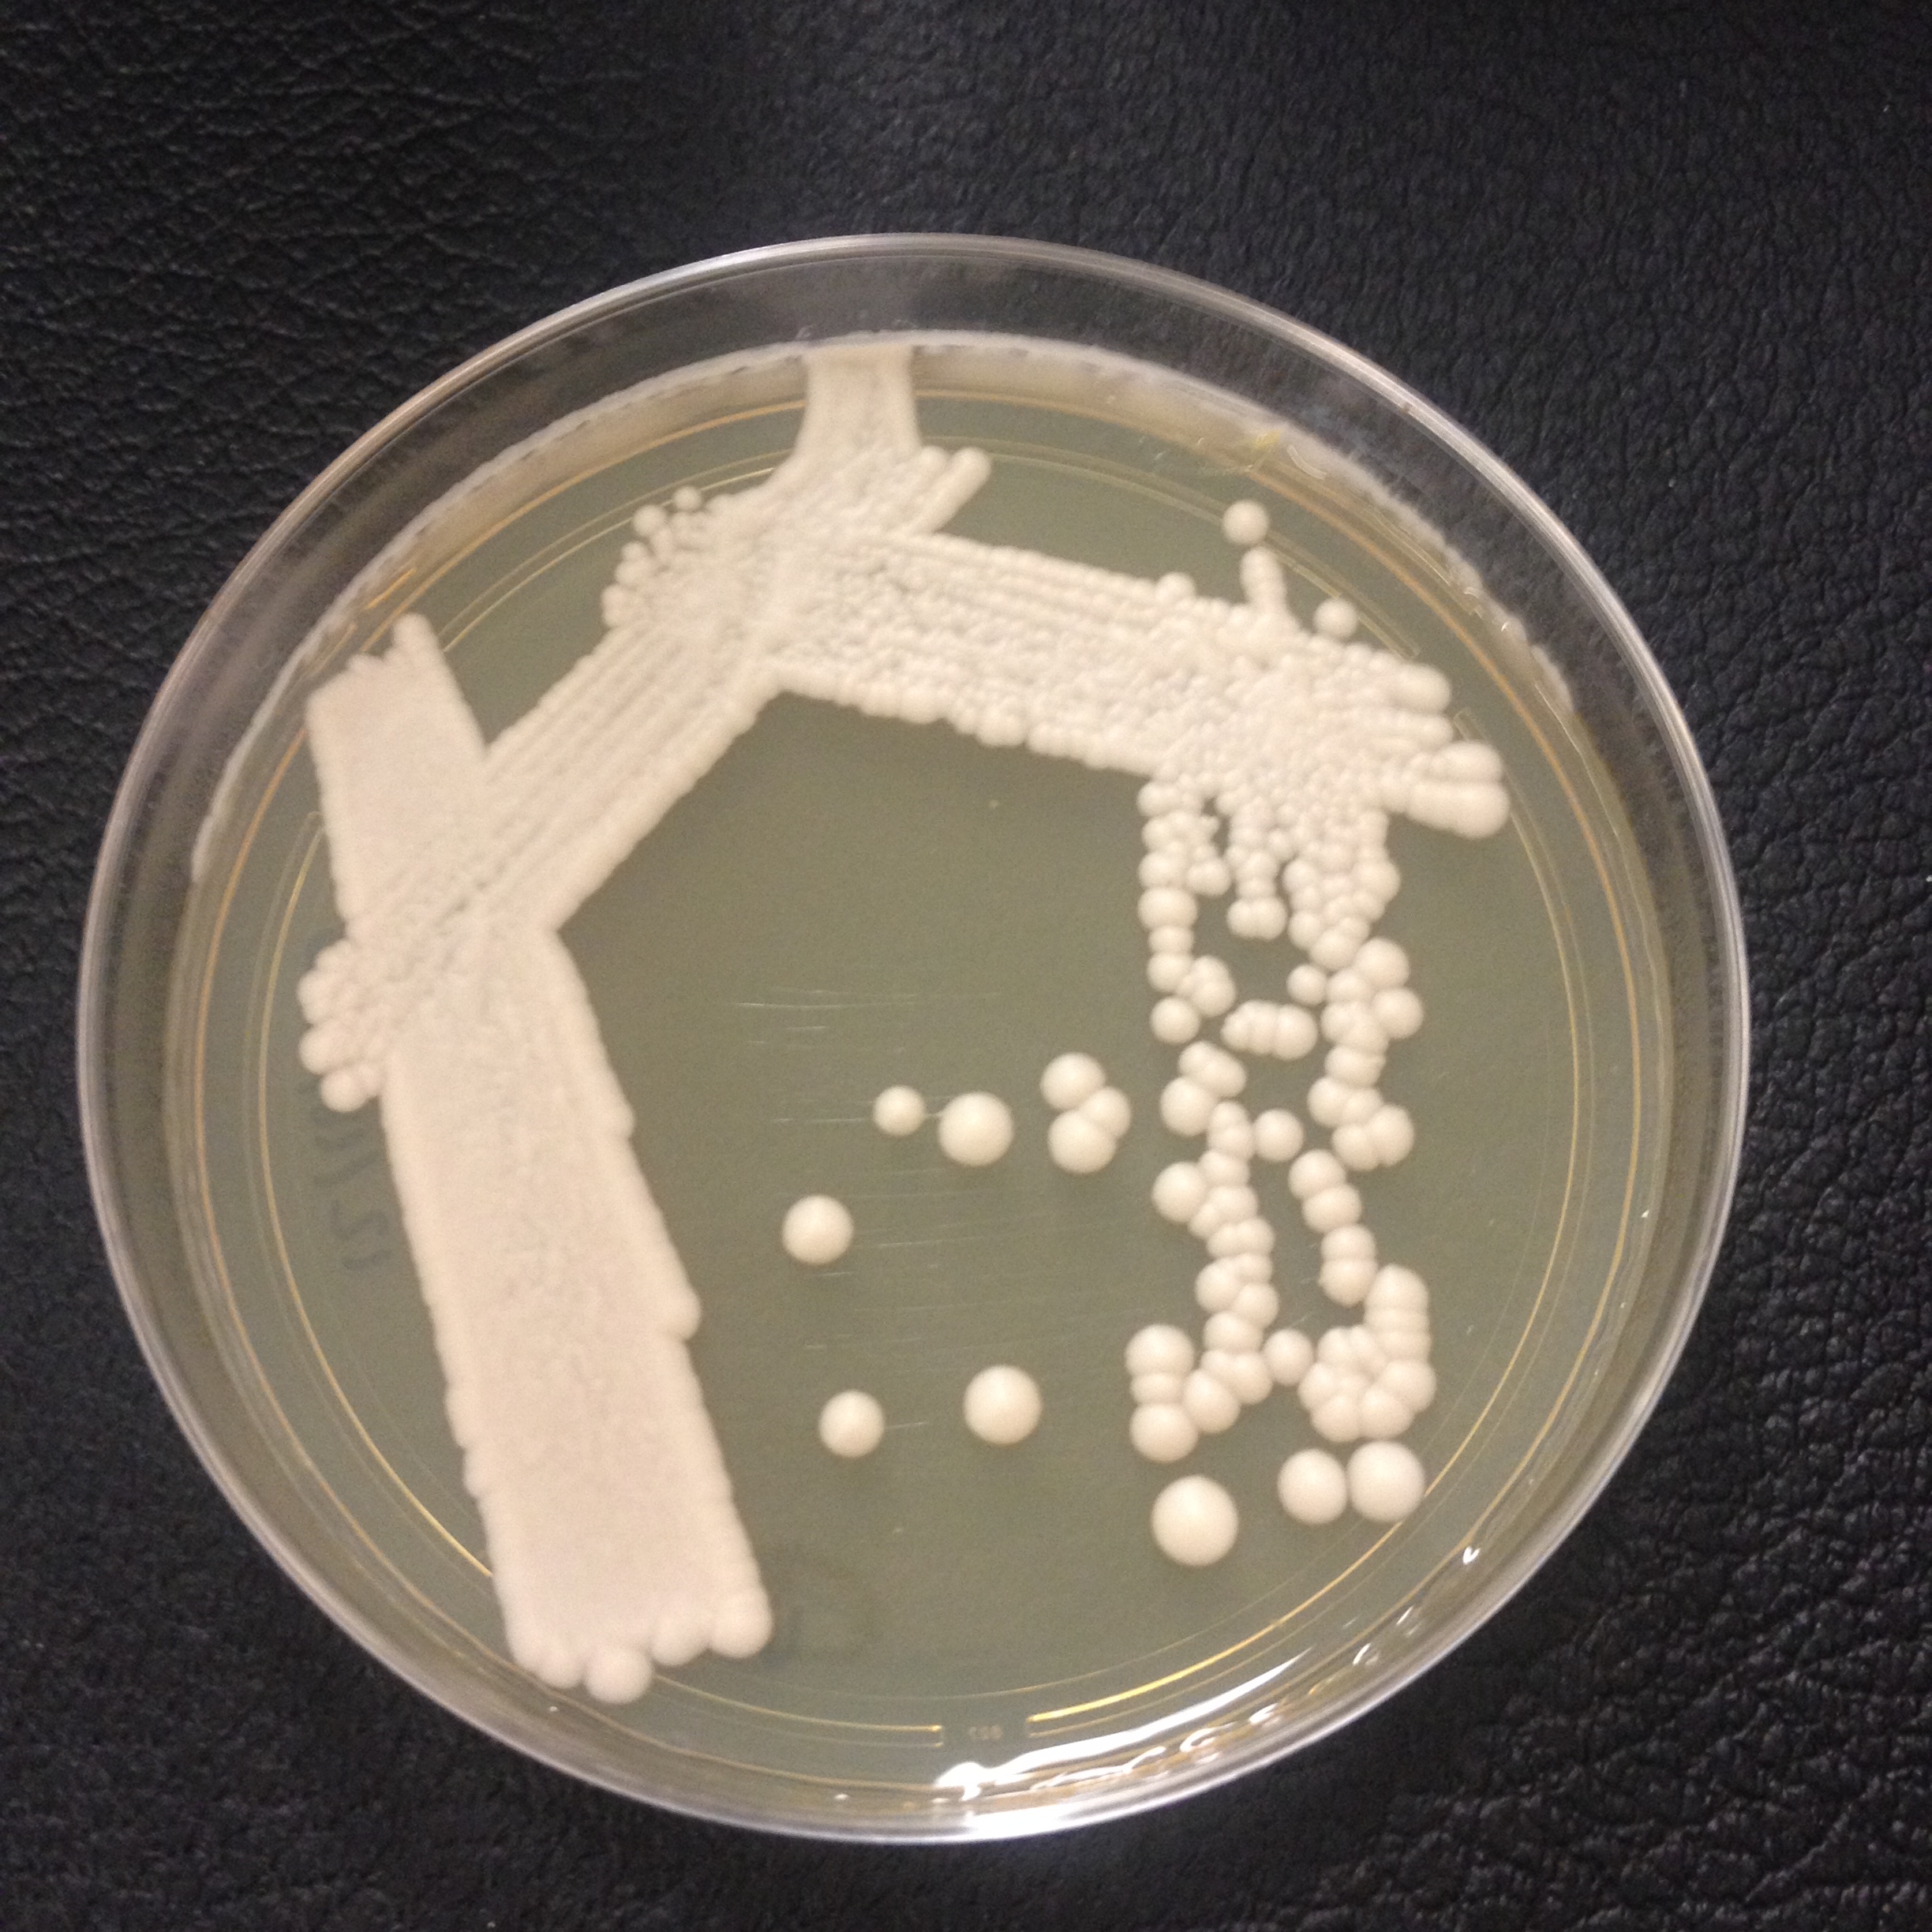

I wanted to take this year-end opportunity, near the perihelion where the Earth is the closest to the sun, to talk about my brewing and blog goals for the upcoming year. I have two big brewing experiments coming up in 2014. The first experiment is focused on different yeasts. I am currently fermenting a test batch of beer with a strain of Saccharomyces paradoxus, a close yeast relative of Saccharomyces cerevisiae, that is not (as far as I know) currently used by any production brewery. These two yeasts are close relatives but have unique fermentation profiles. Look for that post in the first part of the year. There will be additional test batches using a couple of more yeast strains not in common usage currently. I have cultures of Saccharomyces bayanus and Saccharomyces eubayanus as well that may make interesting beers. These tests will be spread out through the year.
I wanted to take this year-end opportunity, near the perihelion where the Earth is the closest to the sun, to talk about my brewing and blog goals for the upcoming year. I have two big brewing experiments coming up in 2014. The first experiment is focused on different yeasts. I am currently fermenting a test batch of beer with a strain of Saccharomyces paradoxus, a close yeast relative of Saccharomyces cerevisiae, that is not (as far as I know) currently used by any production brewery. These two yeasts are close relatives but have unique fermentation profiles. Look for that post in the first part of the year. There will be additional test batches using a couple of more yeast strains not in common usage currently. I have cultures of Saccharomyces bayanus and Saccharomyces eubayanus as well that may make interesting beers. These tests will be spread out through the year.
 The second big experiment of the year revolves around the experiment hops developed in 2013. I purchased a few experiment hop varieties from Yakima Valley Hops (love those guys) with the intention of brewing SMaSH IPAs with them to determine their flavor profiles. The hop varieties I ordered were “Experimental Pine Fruit”, “Experimental Lemon Zest”, ADHA 871, ADHA 483 – Azacca™, and ADHA 484. So there will be five 2.5 gallon IPAs that utilize these hops exclusively this year. These will be brewed as close together as possible.
The second big experiment of the year revolves around the experiment hops developed in 2013. I purchased a few experiment hop varieties from Yakima Valley Hops (love those guys) with the intention of brewing SMaSH IPAs with them to determine their flavor profiles. The hop varieties I ordered were “Experimental Pine Fruit”, “Experimental Lemon Zest”, ADHA 871, ADHA 483 – Azacca™, and ADHA 484. So there will be five 2.5 gallon IPAs that utilize these hops exclusively this year. These will be brewed as close together as possible.
Other than those two experiments (which will generate a lot of interesting and hopefully drinkable beer), I want 2014 to be a year where I push the boundaries of my brewing technique and abilities. I want to explore brewing techniques and styles that I have neglected to attempt. Expect to see more “How to” home brew posts this year (how to make candi sugar, how to wash yeast, how to smoke malt…and so on). My biggest goal of the year, I want to brew my first lagers. My lager goals are to brew an Oktoberfest (not just because I want to see my wife in a drindl) and a Helles this year. I have an old fridge that would work as a lagering chamber but currently it does not have a source of electricity nearby. This is my primary goal for this year, get that up and running this spring / summer.
On the blog front, there will be several postings this year from various breweries around the Virgina / Maryland / DC area. There about half a dozen breweries opening in Washington D.C. and surrounding areas in 2014 and about as many opened in 2013. I have had several wonderful opportunities to talk to brewers and brewery owners in the area over the past few months, getting to know them and taste their test batches. I hope to post interviews with some of these people, learn what they’ve been through opening their breweries and bringing their beers to market.
This year will bring a few additional dimensions to the fermentation side of the blog as well. There will be fermented vegetables (sauerkraut and chile peppers), breads, and possibly cheeses (if I get brave enough). There may be a few posts about gardening that sneak in here as well, but I’ll keep those about vegetables headed for fermentation. A little preview of a post coming up in January…I built a smoker out of an old Buffalo Trace bourbon barrel. This is intended as a meat smoker but I definitely will smoke malt in there as well for a couple of smoke beers that are scheduled for 2014. January is going to be a fun month for the blog.
Beers you can expect to see this year from me: Belgian Tripel, Grätzer (smoked hefeweizen), Scotch Ale, Old ale, Chile beer (with home grown chile peppers), Breakfast stout, Witbier, Altbier, Russian Imperial Stout, Kvas (this will be quite the journey, I promise), and several others. The sour program and the high temp vs. low temp mashing batches will continue as well. A busy year with lots of (hopefully) great beer. Happy brewing, enjoy your Christmas Gueuze and I’ll see you in 2014!
Now, trice welcome Christmas, which brings us good cheer; mince pies and plum pudding; strong Ale and strong Beer. – unknown, circa 1700

2 thoughts on “Happy Winter Apsis! Brewing Goals for 2014.”